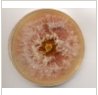

Strain
Search
All Fusarium strains
Fusarium Genomes Research Group Statutes
Genome Projects
Cyberinfrastructure for Fusarium
The Fusarium comparative genomics database
5/8/13
The 2013 Fusarium Genetics Workshop was held in conjunction with the 27th Fungal Genetics Conference at Asilomar, Pacific Grove, CA on Tuesday, March 12, 2013. The scientific program was put together by Martijn Rep (University of Amsterdam) and Michael Freitag (Oregon State University). Site organization and co-ordination was by Anne Marie Mahoney (Genetics Society of America). Program details are available online, as is a photograph of workshop participants (taken by Peter van Dam, University of Amsterdam
4/9/12
The 2012 Fusarium Genetics Workshop was held at the Max-Planck-Institute in Marburg, Germany on Friday, March 30, 2012. The meeting was moderated by the meeting organizer Bettina Tudzynski. The program included three sessions: Host-Fungal Interactions (chaired by Antonio Di Pietro), Secondary Metabolism (chaired by Dr. Tudzynski) and Genomics (chaired by Corby Kistler). The notes from the meeting are available online.
4/14/11
The minutes from the 2011 business meeting are available online.
The next fusigroup meeting will be in Marburg, Germany, 30th of March 2012 as a satellite to the 11th European Conference on Fungal Genetics. Prof. Dr. Bettina Tudzynski will be the local organizer.
3/22/11
There has been a request to host some of the presentations from the 2011 Fusarium Workshop at Asilomar on the web. Please find them here:
LiJunFusarium_Asilomar2011.pdf
11/9/10
The 2011 Fusarium Workshop will be held in conjunction with the 26th Fungal Genetics Conference at Asilomar. The Fusarium meeting will be held in the late morning and early afternoon of Tuesday, March 15, 2011, before the Social Reception (Mixer) of the Fungal Genetics Conference. Please make individual arrangements for housing on the night of March 14. with the Asilomar Conference Center (www.visitAsilomar.com). We are looking forward to seeing you there!
H.
Corby Kistler and Cees Waalwijk
Meeting Co-organizers
2/25/09
1/22/09
Registration for the
2009 Fusarium Laboratory Workshop at Kansas State University is now
available.
The FGSC is a new sponsor for this meeting.
12/4/08
Asilomar 2009: There will be an ad hoc session of the Fusarium Researchers Sunday morning, the last morning of the Fungal Genetics Conference from 9 am to noon. Organizer: Bob Proctor, Peoria, IL USA.
4/14/08
Abstracts from the ECFG are available online. A synopsis of those mentioning Fusarium is available here (Courtesy of Hans VanEtten).
3/22/08
The Broad released the Fusarium comparative web site to enhance the comparative functions.
3/12/08
The Fusarium Genomes Research Group Statutes were posted on the FGSC website.
For information about Chip availability, please contact Frances Trail
The next Fusigroup meeting will be at
the 10th
International Fusarium Workshop and Fusarium Genomics Workshop 2008
which is being held as a satellite to the
9th International Congress on Plant
Pathology in Torino Italy, August 24-29, 2008.
The USDA has updated their permit process for genetically engineered
plant pathogens.
Following re-organization in the BRS, their most recent statement says
that one does not need a permit to work with genetically engineered
Plant Pathogenic Fungi, but that one needs a permit to transport them.
The permit is online here:
http://www.aphis.usda.gov/permits/brs_epermits.shtml
4/17/07
There are a number of ways to search for Fusarium at the FGSC web-site.
The FGSC holds 531 Fusarium strains as well as gene libraries, cloned genes, transformation vectors and RFLP probes. We also have the BAC and Fosmid libraries from the Broad Institute F. graminearum genome project.
At the 24th Fungal Genetics Conference at Asilomar, the FGSC published the following:
To the Greater Fusarium Research Community,
The Fungal Genetics Stock Center has for a number of years accepted and maintained a number of Fusarium strains as well as resources for working with Fusarium.
Because the USDA regulates work with Fusarium, we have maintained permits for receiving and holding Fusarium strains. Our current permit imposes a number of limitations on us including the following:
"Receipt and culture of foreign isolates is not authorized under this permit"
"This permit does not authorize the introduction, importation, interstate movement, or release into the environment of any genetically engineered organisms or products"
An earlier permit authorized the FGSC to move and import isolates from "worldwide sources to Kansas to be placed in a culture collection" and we received a permit to move the collection from Kansas to Missouri.
Because the newer permits are more stringent in their requirements, and because most modern research with filamentous fungi involves genetic engineering, we are seeking to involve the Fusarium research community in decisions pertaining to our maintenance of existing materials and acceptance of new materials, as we have done with other communities such as the Aspergillus community and Magnaporthe community. The Policy Statement of the Magnaporthe Advisory Committee is available as a guideline.
Prior to expanding a collection beyond a few type strains, we request the members of a community to develop an Advisory Board to the FGSC to define criteria to determine what strains and materials should be maintained by the stock center, who will be the keeper of a backup copy of the collection and to attempt to secure funding to assist the Stock Center.
This is also more important as a number of researchers with extensive collections are facing retirement in the next ten years.
Because we do not have an Advisory Committee for Fusarium and because of the issues surrounding work with genetically engineered strains, the FGSC will no longer accept for deposit or distribute strains whose status is questionable because of their genotype or origin.
We have been informed by the USDA that genome libraries or individual clones from such libraries are not considered to be "genetically engineered products." As such, we will continue to distribute cloned Fusarium material as well as genomic DNA from Fusarium.
Finally, as there are three collections in the US that accept Fusarium for deposit, we would like to ensure that resources are deposited in the most appropriate and accessible collection.
3/7/07 KMC
The USDA Biotechnology Regulatory Services (BRS) issued its Spring 2007 Stakeholder Update where they announced that they are undergoing a major revision of their how they regulate genetically engineered organisms. They say:
"BRS is undertaking a major revision of its guidance on the regulation of GE organisms. The project will update and consolidate all agency guidance related to compliance with APHIS’ biotechnology regulations (7 CFR 340) into a single printed publication, entitled the BRS User’s Guide. In January 2007, the first two chapters of the new BRS User's Guide were posted online. These include a chapter on document preparation guidelines, including how to handle CBI, and guidance for notifications. As BRS completes new guidance chapters they will also be placed online, until all existing guidance is replaced with new guidance. All BRS User’s Guide chapters are available at
http://www.aphis.usda.gov/brs/brs_usersguide.html"The last time the regulations were updated was November 1996. Officially "Developers and researchers may petition APHIS to remove the regulated organism from BRS oversight, " but the petition process is geared entirely toward crop plants.
This is an important time to weigh in with your opinion about how genetically engineered plant pathogenic fungi are regulated. Registering as a BRS Stakeholder is a first step towards being better informed about this important issue. Contacting your Senator or Congress Representative is another way to be heard. You can also contact the USDA Biotechnology Regulatory Services directly.
4/17/07 KMC